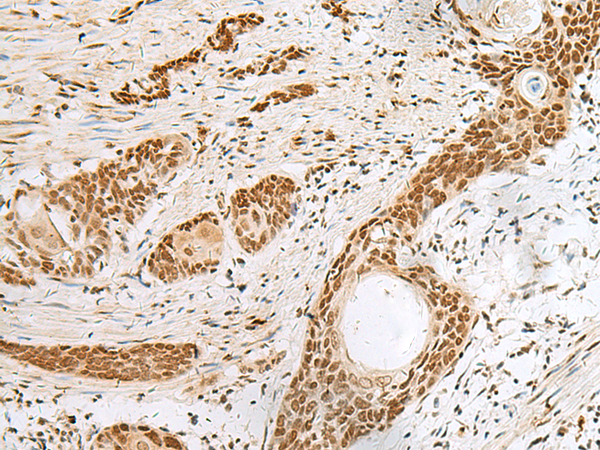

中文名稱 : 兔抗PNRC2多克隆抗體
英文名稱 : Anti-PNRC2 rabbit polyclonal antibody
別 名 : proline rich nuclear receptor coactivator 2
儲(chǔ) 存 : 冷凍(-20℃)
抗 原 : PNRC2
宿 主 : Rabbit
相關(guān)類別 : 一抗
反應(yīng)種屬 : Human, Mouse, Rat
標(biāo) 記 物 : Unconjugate
克隆類型 : rabbit polyclonal
技術(shù)規(guī)格
|
Background: |
Involved in nonsense-mediated mRNA decay (NMD) by acting as a bridge between the mRNA decapping complex and the NMD machinery (PubMed:19150429). May act by targeting the NMD machinery to the P-body and recruiting the decapping machinery to aberrant mRNAs (PubMed:19150429). Required for UPF1/RENT1 localization to the P-body (PubMed:19150429). Plays a role in glucocorticoid receptor-mediated mRNA degradation by interacting with the glucocorticoid receptor NR3C1 in a ligand-dependent manner when it is bound to the 5' UTR of target mRNAs and recruiting the RNA helicase UPF1 and the mRNA-decapping enzyme DCP1A, leading to RNA decay (PubMed:25775514). Also acts as a nuclear receptor coactivator (PubMed:11574675). May play a role in controlling the energy balance between energy storage and energy expenditure (By similarity). |
|
Applications: |
ELISA, IHC |
|
Name of antibody: |
PNRC2 |
|
Immunogen: |
Fusion protein of human PNRC2 |
|
Full name: |
proline rich nuclear receptor coactivator 2 |
|
SwissProt: |
Q9NPJ4 |
|
ELISA Recommended dilution: |
5000-10000 |
|
IHC positive control: |
Human cervical cancer and Human colorectal cancer |
|
IHC Recommend dilution: |
50-300 |

購物車
幫助
021-54845833/15800441009
